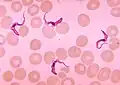

Ser vivo
.jpg.webp)
Los seres vivos agrupan todos los organismos que pueblan nuestro planeta: los animales, los hongos, las bacterias, las plantas.... Hay una multitud de ellos, y no es necesariamente muy fácil dar una definición que se ajuste a todos ellos.
Información
Los seres vivos se distribuyen en la superficie de toda la Tierra es decir, ocupan la parte continental del planeta y la parte que corresponde a las aguas oceánicas, los mares, ríos, lagos y lagunas; algunos también viven en la parte inferior de la atmósfera.
Los seres vivos son muy variados; por ejemplo, algunos son extremadamente pequeños, como las bacterias y otros de gran tamaño, como las ballenas, o por ejemplo también hay animales que habitan en ambientes acuáticos, cómo los peces, y otros en los ambientes aeroterrestres, como las aves.
Un ser vivo se desarrolla en un ambiente, en el cuál el ser vivo puede vivir gracias a sus características adaptativas, que les permite vivir y desarrollarse en determinados lugares.
Clasificación
Se clasifican en cinco reinos:
- El reino animal: a él pertenecen los animales. Nosotros estamos incluidos dentro de este reino.
- El reino vegetal: contiene las plantas.
- El reino monera: agrupa a las bacterias y organismos microscópicos.
- El reino fungi: incluye a los hongos.
- El reino protoctista: incluye protozoarios.
Definición
Un ser vivo es un organismo que está dotado de vida: esto quiere decir que es un organismo que cumple con las siguientes características:
- Nace: la existencia de este organismo tiene un principio, el nacimiento, lo que quiere decir que este organismo que existe en un momento no ha existido siempre y no existía forzosamente antes; por ejemplo, un bebe nace, un pájaro eclosiona de su huevo, una semilla germina...
- Crece: con el curso del tiempo, el tamaño de este ser vivo se modifica después de su nacimiento; fabrica materia orgánica de la que su cuerpo está constituido.
- Se alimenta: los seres vivos no son capaces de fabricar su materia a partir de nada: deben encontrar, en su medio, materia a partir de la cual puedan constituir sus cuerpos, para crecer: algunos pueden utilizar materia mineral contenida en su medio ambiente (el agua, los gases contenidos en el aire, las sales minerales...) Por eso, las plantas, por ejemplo, son llamadas productores primarios; otros no pueden transformar la materia mineral en materia orgánica: deben pues consumir la materia orgánica de otros seres vivos, vivos o muertos. Se les llama productores secundarios.
- Muere: la existencia de un ser vivo puede ser muy corta o muy larga, pero tiene siempre un "fin" de una manera o de otra, lo que quiere decir que muere.
Casos particulares
Todos los seres vivos deben responder precisamente a los cinco puntos de esta definición, si no, no son verdaderamente seres vivos. Por ejemplo, los virus no son capaces de producir otros virus, es decir de reproducirse: son solamente capaces de forzar a las células de otros seres vivos a fabricar nuevos virus, no los fabrican verdaderamente ellos mismos: no se puede pues hablar de reproducción. Los virus no son pues seres vivos.
Caracteres comunes a todos los seres vivos
La célula
Todos los seres vivos están formados por el mismo elemento base: la célula. Un ser vivo puede estar formado de un muy gran número (a menudo varios millones) de células, o incluso de una sola, pero estará siempre formado de al menos una célula. Un ser vivo formado de una sola célula se llama unicelular.
De hecho, un muy gran número de seres vivos diferentes están formados por una sola célula, y, como la célula es a menudo algo microscópico, estos seres vivos lo son también, y no son pues visibles a simple vista. Se les llamaba algunas veces microbios, pero se prefiere hoy utilizar la palabra de microorganismo. Los microorganismos son seres vivos que no tienen necesariamente gran cosa en común, excepción hecha de su muy pequeño tamaño, que les impide ser visibles a simple vista.
Existe un muy gran número de células diferentes, que no se parecen necesariamente, pero todas estas células presentan las características que permiten clasificarlas como seres vivos.
Productores y consumidores
Todos los seres vivos están formados de materia orgánica. Utilizan la materia contenida en su medio ambiente para producir su propia materia orgánica: es decir que ellos se alimentan. Hay dos tipos de seres vivos:
- Los que se alimentan de materia mineral: agua, algunos gases, como el dióxido de carbono, el metano o el sulfuro de hidrógeno. Son capaces de transformar la materia mineral de su medio ambiente en materia orgánica. No tienen pues necesidad de materia orgánica, ni así pues de otros seres vivos para alimentarse: pueden vivir solos. Estos son siempre los primeros seres vivos en colonizar un medio nuevo donde la vida esta ausente: se les llama productores primarios. Los productores primarios tienen necesidad de energía para transformar la materia mineral en materia orgánica. Los mas conocidos son los que utilizan la luz para transformar el agua y el dióxido de carbono en materia orgánica. Este fenómeno se llama fotosíntesis. Los vegetales y ciertos flagelados, especialmente, tienen capacidad de fotosíntesis. Pero hay otros productores primarios que utilizan otras fuentes de materia mineral y energía.
- Los que se alimentan de la materia orgánica de los otros seres vivos: estos no son capaces de transformar la materia mineral en materia orgánica: ellos deben utilizar la materia orgánica de otros seres vivos para fabricar la suya. Se les llama productores secundarios, pues tienen necesidad de productores primarios para poder existir. Los productores secundarios no pueden vivir en un medio donde no hay productor primario para alimentarles. Se les llama también consumidores.
Hay dos tipos de productores secundarios: los que se alimentan exclusivamente de productores primarios, así como los que tienen necesidad de la presencia de productores primarios para vivir: se les llama consumidores primarios, y los que se alimentan de otros productores secundarios: se les llama consumidores secundarios. Los productores secundarios pueden matar a otros seres vivos para alimentarse de su materia orgánica: son los depredadores. Otros pueden alimentarse de la materia orgánica de los seres vivos muertos: son los carroñeros.
La clasificación de los seres vivos
Los seres vivos mas conocidos son los que tienen un gran número de células, porque son más grandes, y así pues son más fáciles de observar. Estos son particularmente, los animales y los vegetales. Antes, estos dos grupos eran los únicos utilizados para clasificar a los seres vivos. Pero se sabe hoy que los hongos, que se les clasificaban entre los vegetales, son de hecho muy diferentes, especialmente, por el funcionamiento de sus células. Finalmente, se parecen máas a los animales que a los vegetales. Ha sido necesario colocarlos en un grupo aparte, el grupo de los hongos.
Se ha descubierto igualmente que el grupo de vegetales llamado "algas" no eran un verdadero grupo, y que se los había mezclado con seres vivos que no tenían gran cosa en común, aparte del hecho de crecer bajo el agua.
- verdaderos vegetales acuáticos, las algas verdes
- primos de los vegetales, las algas rojas
- y seres vivos que no tienen nada que ver, las algas pardas.
Finalmente, hay cinco grandes grupos de seres vivos visibles a simple vista.
- los animales
- los hongos
- los vegetales (como las algas verdes)
- las algas rojas
- y las algas pardas.
A todos estos seres vivos, es preciso añadir los que no son visibles a simple vista, y que han sido descubiertos gracias a la invención del microscopio. Antonio van Leeuwenhoek les dio el nombre de "microbio", lo que quiere decir "pequeño ser vivo", pero hoy se utiliza más bien el termino microorganismo.
Los microorganismos han sido a menudo considerados como un nuevo grupo e incluso hoy, se conserva a veces este grupo de microorganismos pues es práctico para su estudio.
Sin embargo, hay de echo cantidad de grupos enteros de seres vivos que no existen jamás bajo la forma de organismos de varias células, y que no se los ha visto nunca a simple vista.
Se divide a los seres vivos en grandes grupos llamados divisiones, o reinos, en el interior de los cuales se les puede clasificar.
Estos reinos comprenden especialmente:
- División de las procariotas: seres vivos cuyas células no tienen núcleo:
- las bacterias
- las arqueas, que viven incluso en los medios más extremos.
- División de las eucariotas: Seres vivos cuyas células tienen un núcleo:
- los animales (incluidos los insectos y el hombre son de hecho animales en el sentido biológico del término)
- los hongos: hay que son visibles a simple vista, y otros unicelulares y microscópicos.
- los vegetales, que se caracterizan especialmente por su color verde
- las algas rojas
- las algas pardas
- las amebas, casi todas microscópicas
- los ciliados, organismos unicelulares, y cuyas células están cubiertos de especies de pequeños pelos llamados cilios
- los flagelados, que se desplazan por medio de un largo filamento llamado flagelo.
- las dinofitas, que son parte del plancton.
- los esporozoitos, varios de los cuales son responsables de graves enfermedades, como el paludismo.
- las foraminiferas
- las radiolarias
Galería de seres vivos
 Un animal: el ser humano
Un animal: el ser humano Un vegetal: la orquidea
Un vegetal: la orquidea Un hongo, el Lycoperdon perlatum
Un hongo, el Lycoperdon perlatum Una bacteria: el colibacilo
Una bacteria: el colibacilo Un flagelado: el tripanosoma
Un flagelado: el tripanosoma Un alga marrón: el fucus
Un alga marrón: el fucus Una seta: Penicilium camembertii, que forma la corteza del queso Brie
Una seta: Penicilium camembertii, que forma la corteza del queso Brie Un vegetal: la palmera datilera
Un vegetal: la palmera datilera Un alga roja: Chondrus crispus
Un alga roja: Chondrus crispus Un ciliado, el stentor
Un ciliado, el stentor Un ser vivo extraño, la flor de tan: primero considerado como un hongo, hoy está colocado en el grupo de las amebas.
Un ser vivo extraño, la flor de tan: primero considerado como un hongo, hoy está colocado en el grupo de las amebas. Un fósil de Eurypteride, un ser vivo que ha desaparecido
Un fósil de Eurypteride, un ser vivo que ha desaparecido